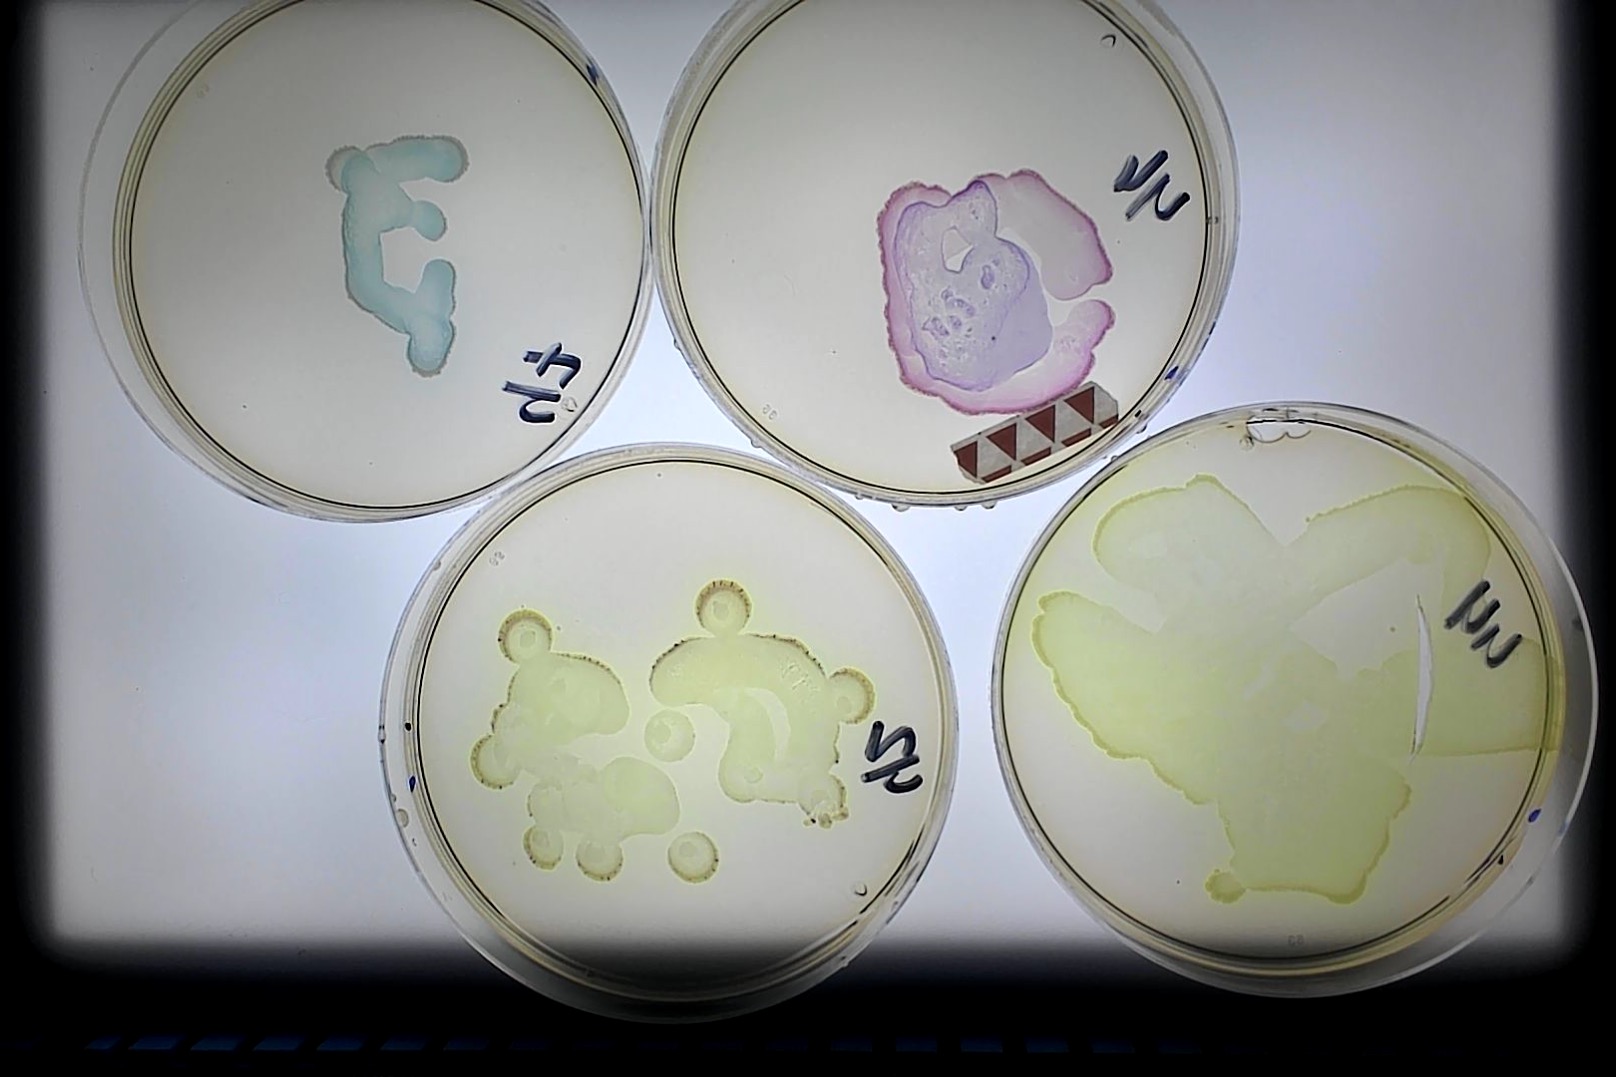
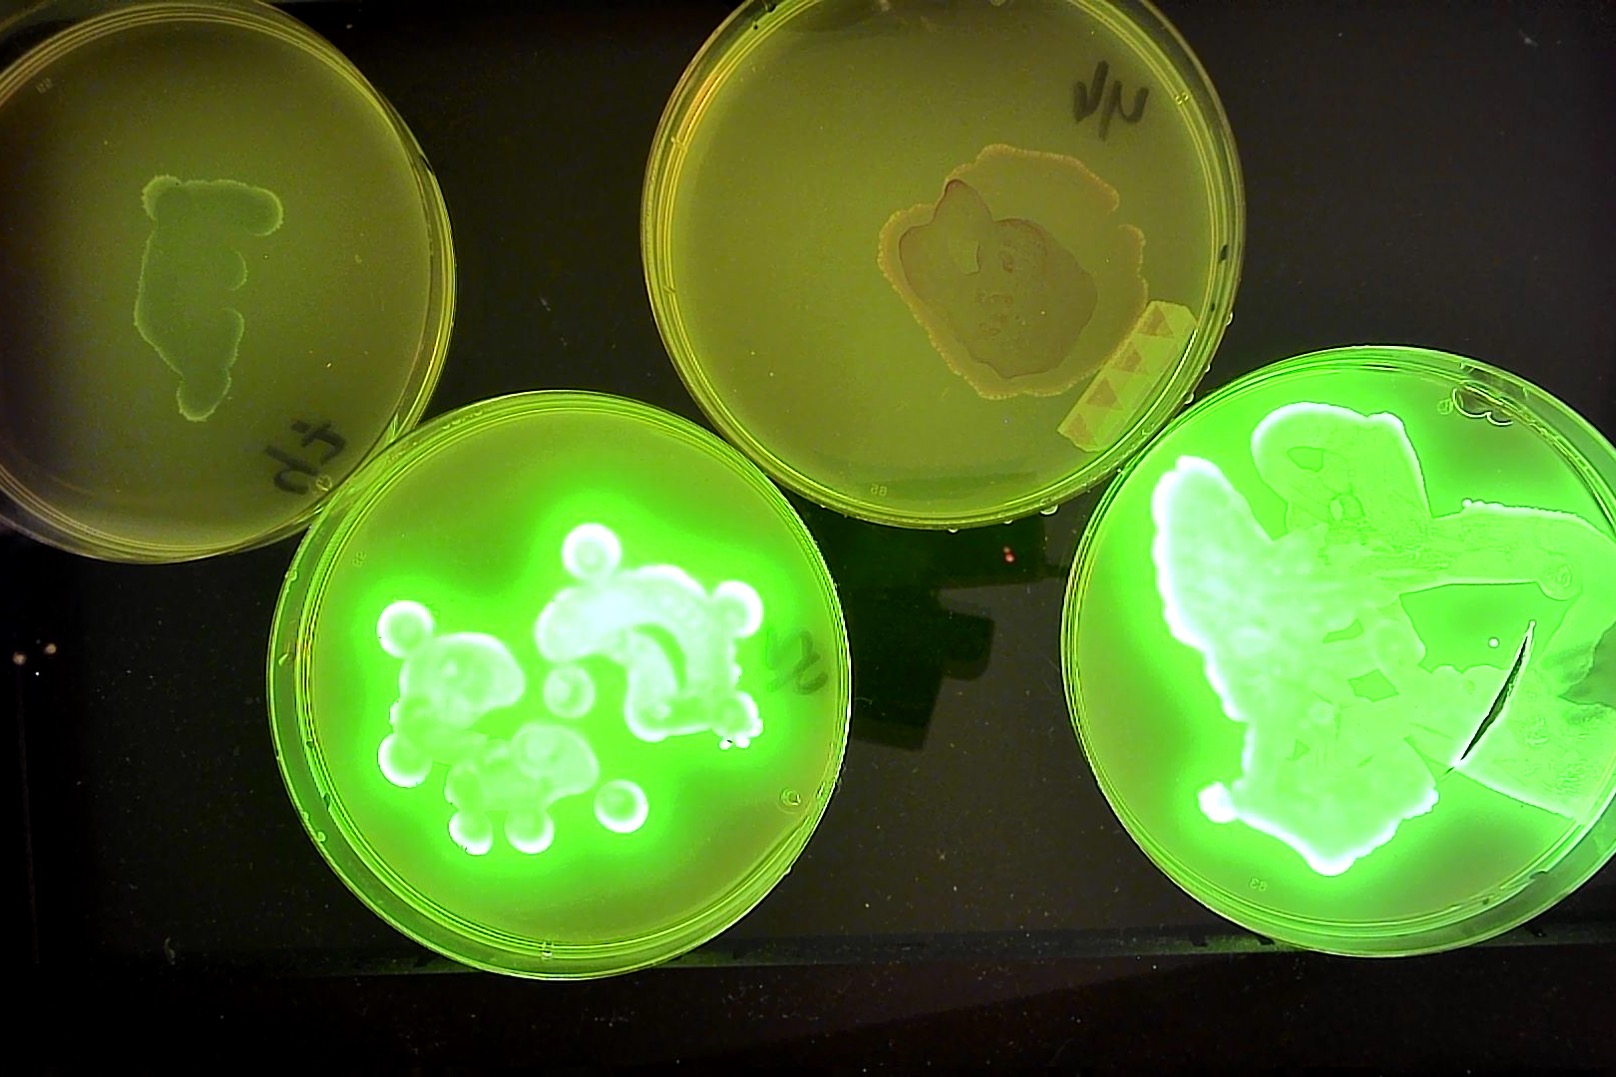
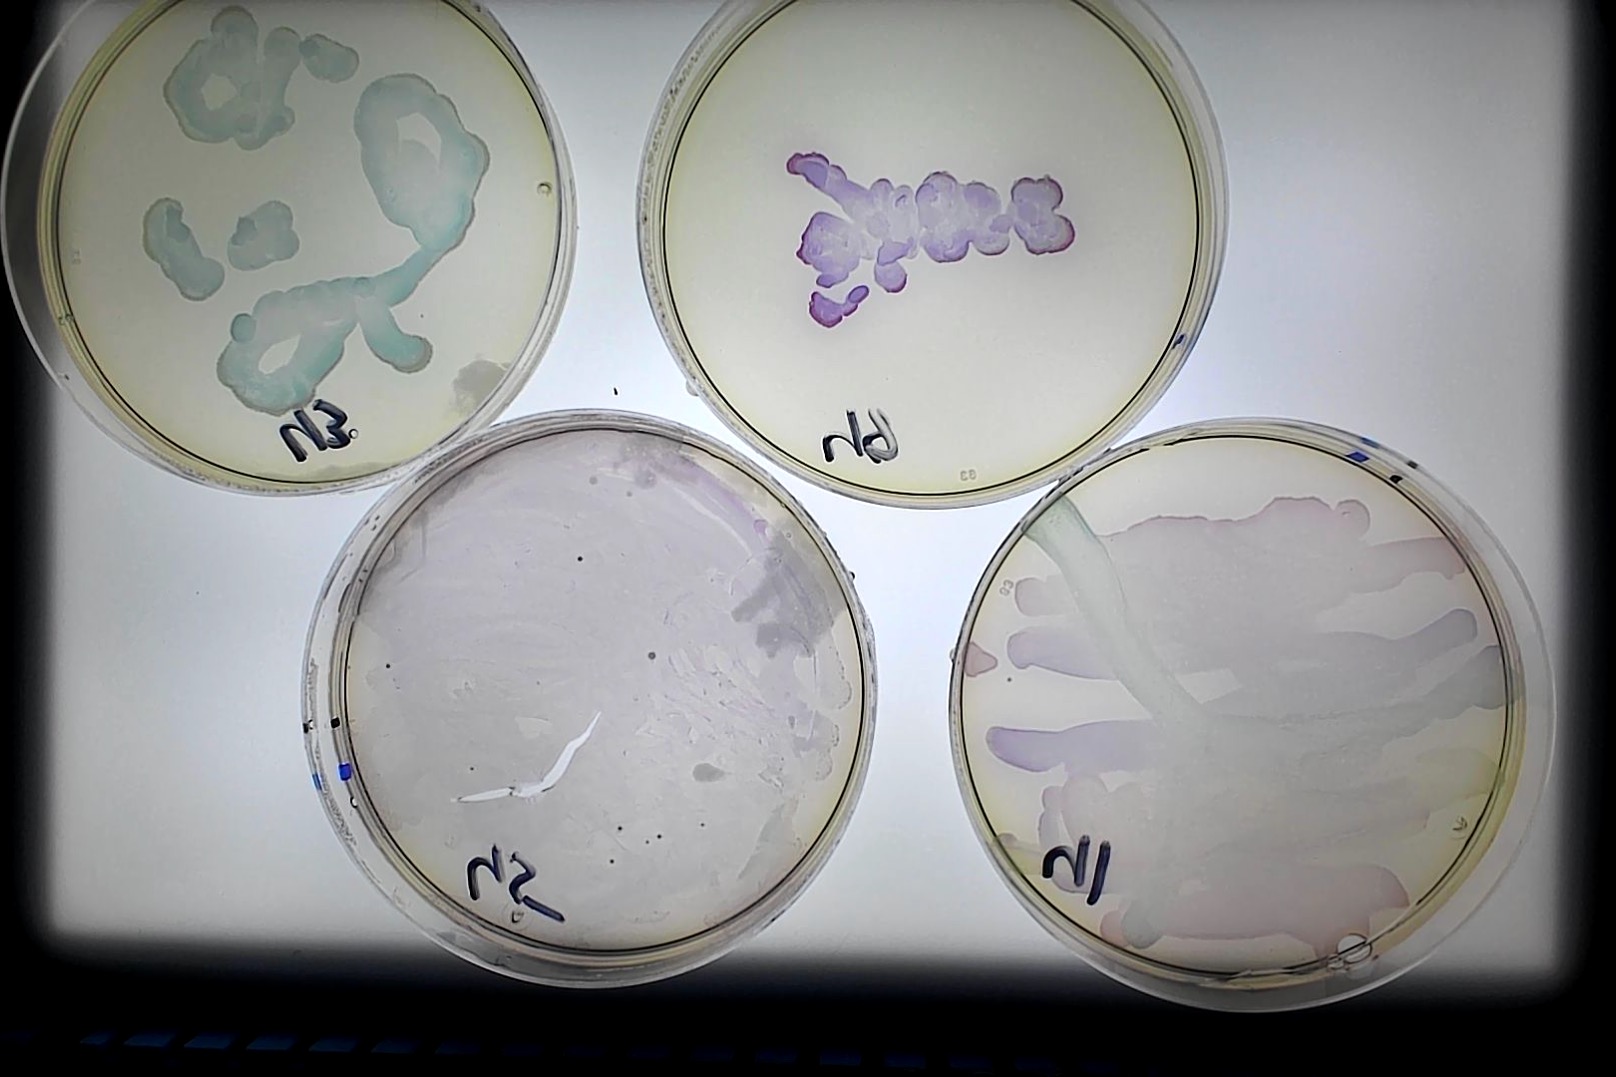
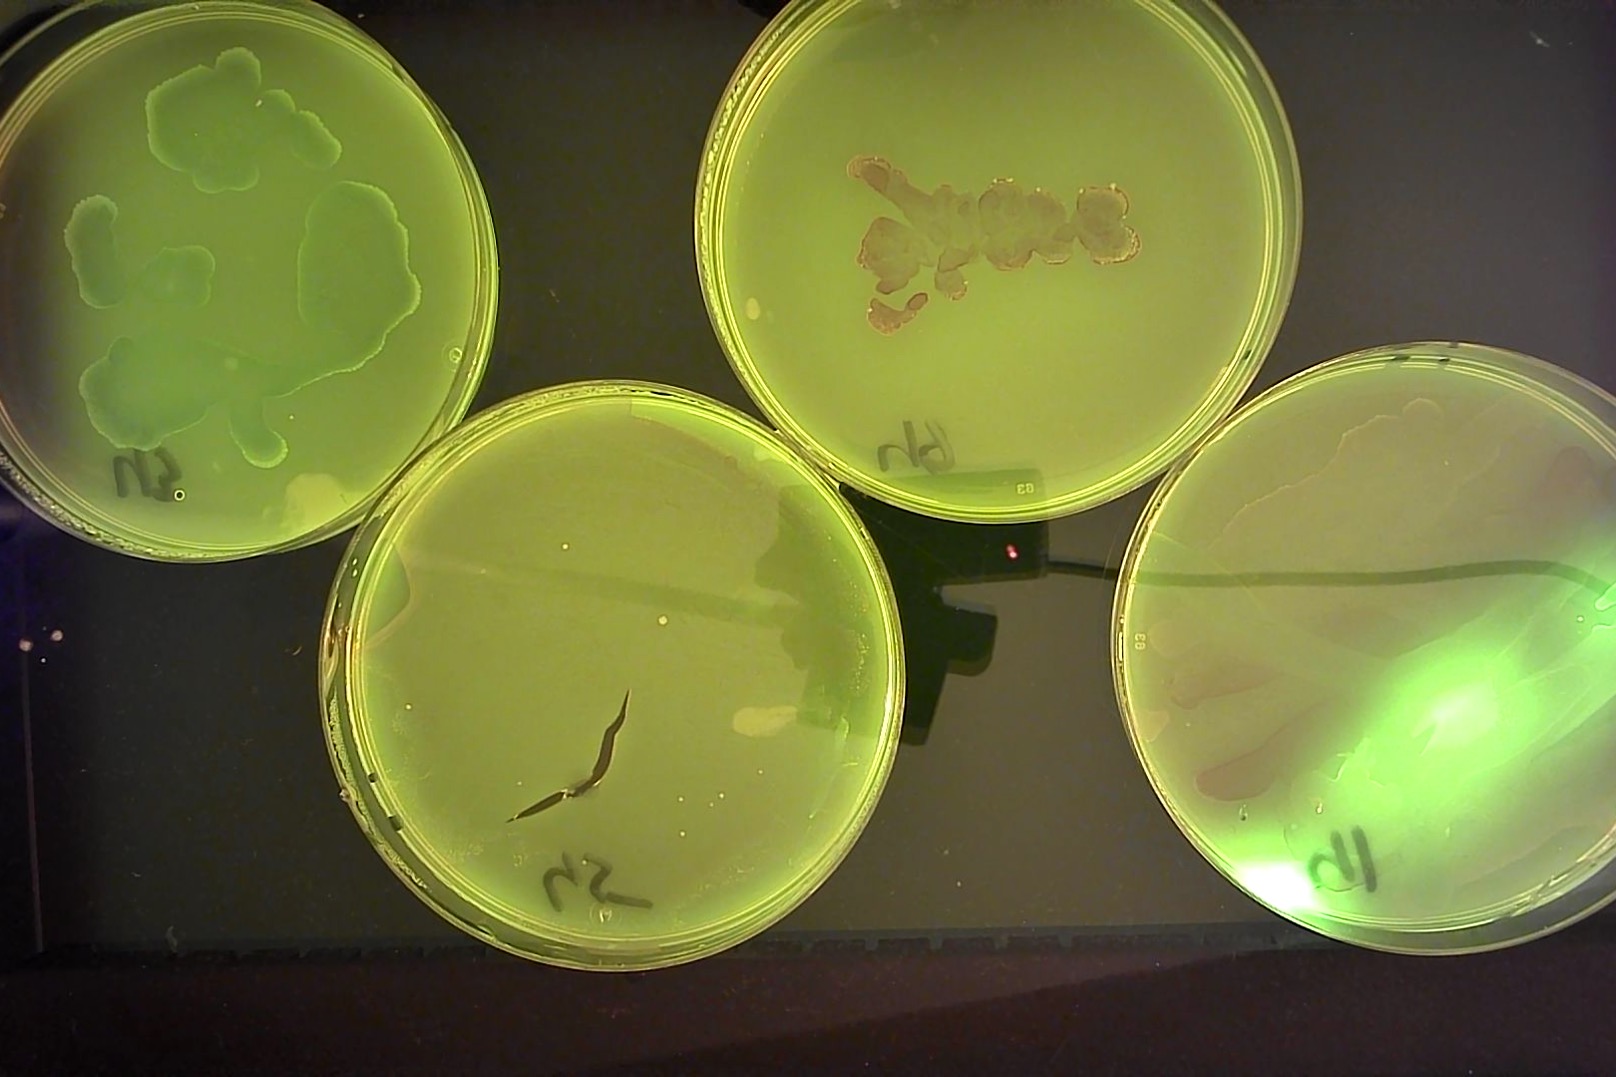
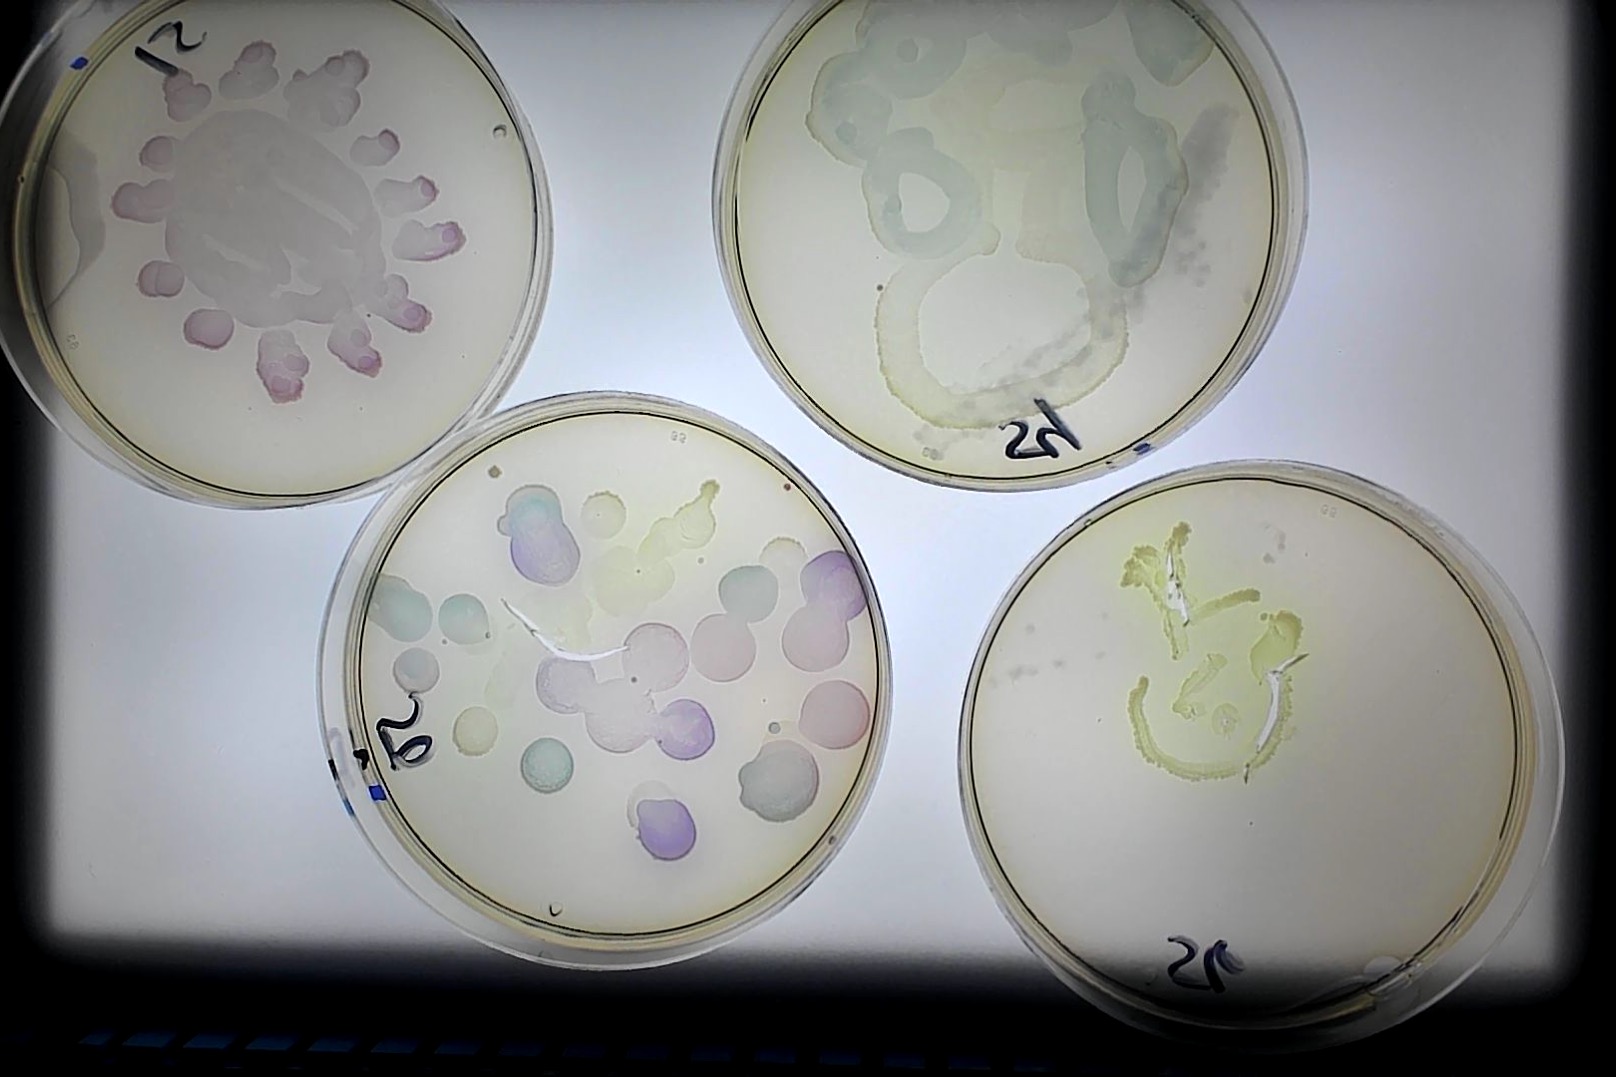
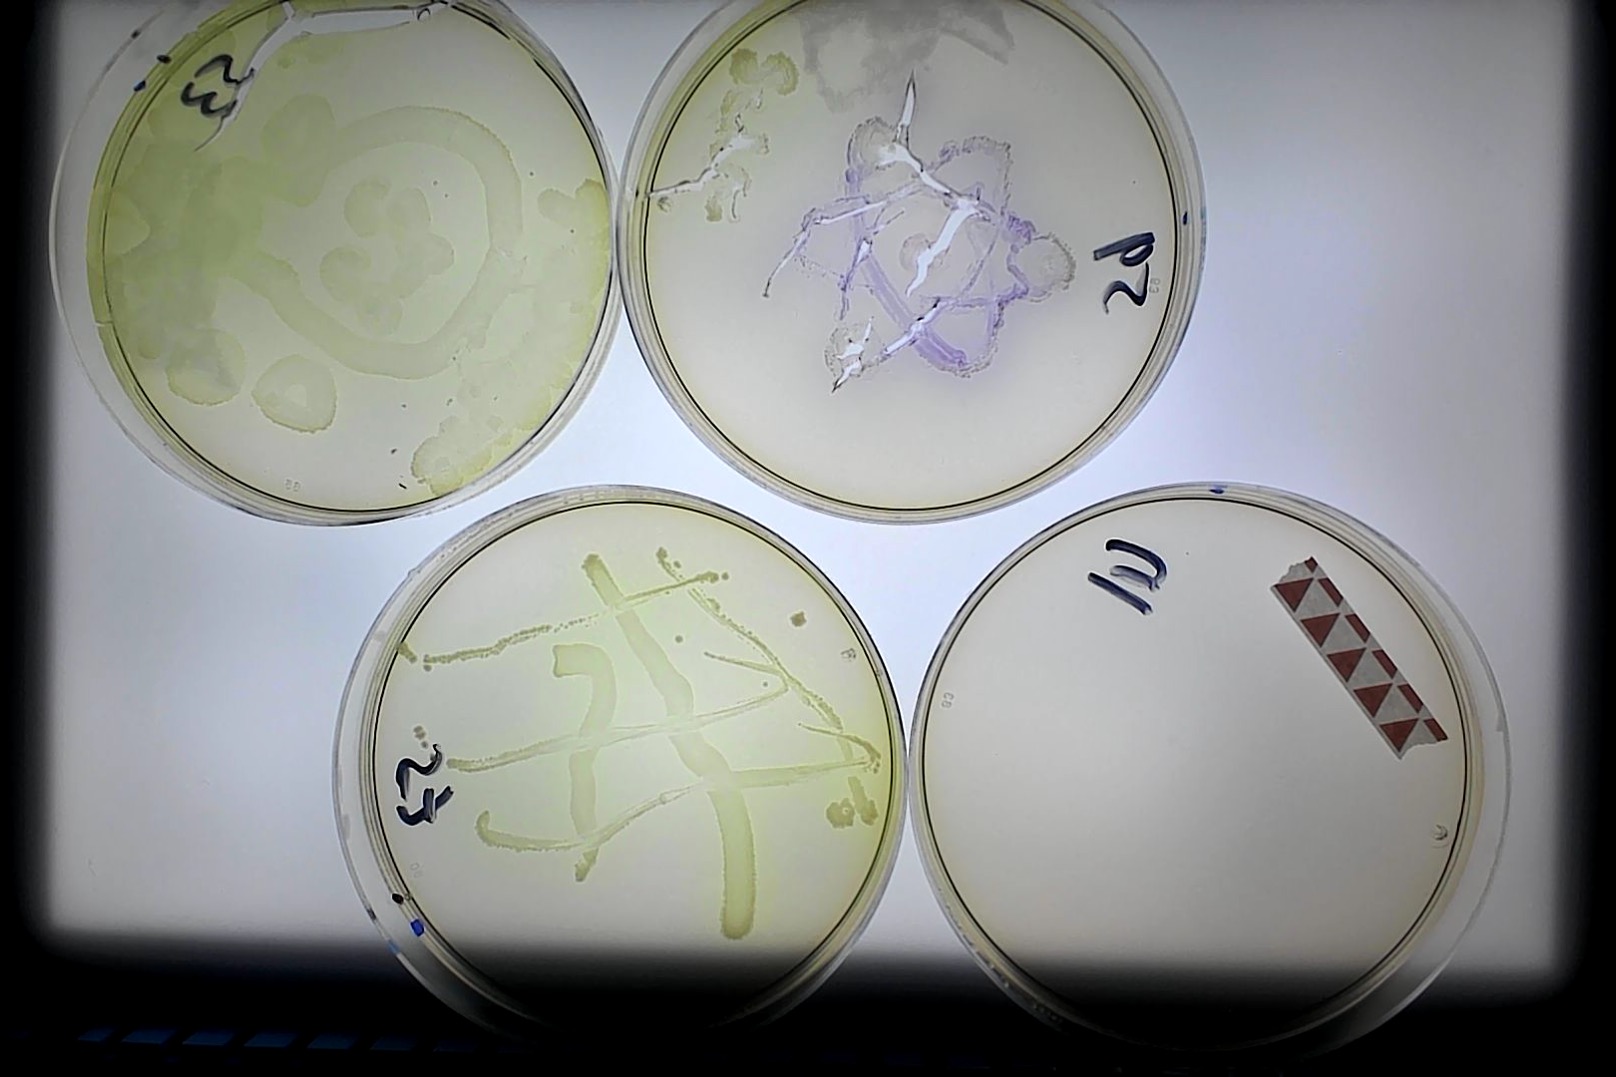
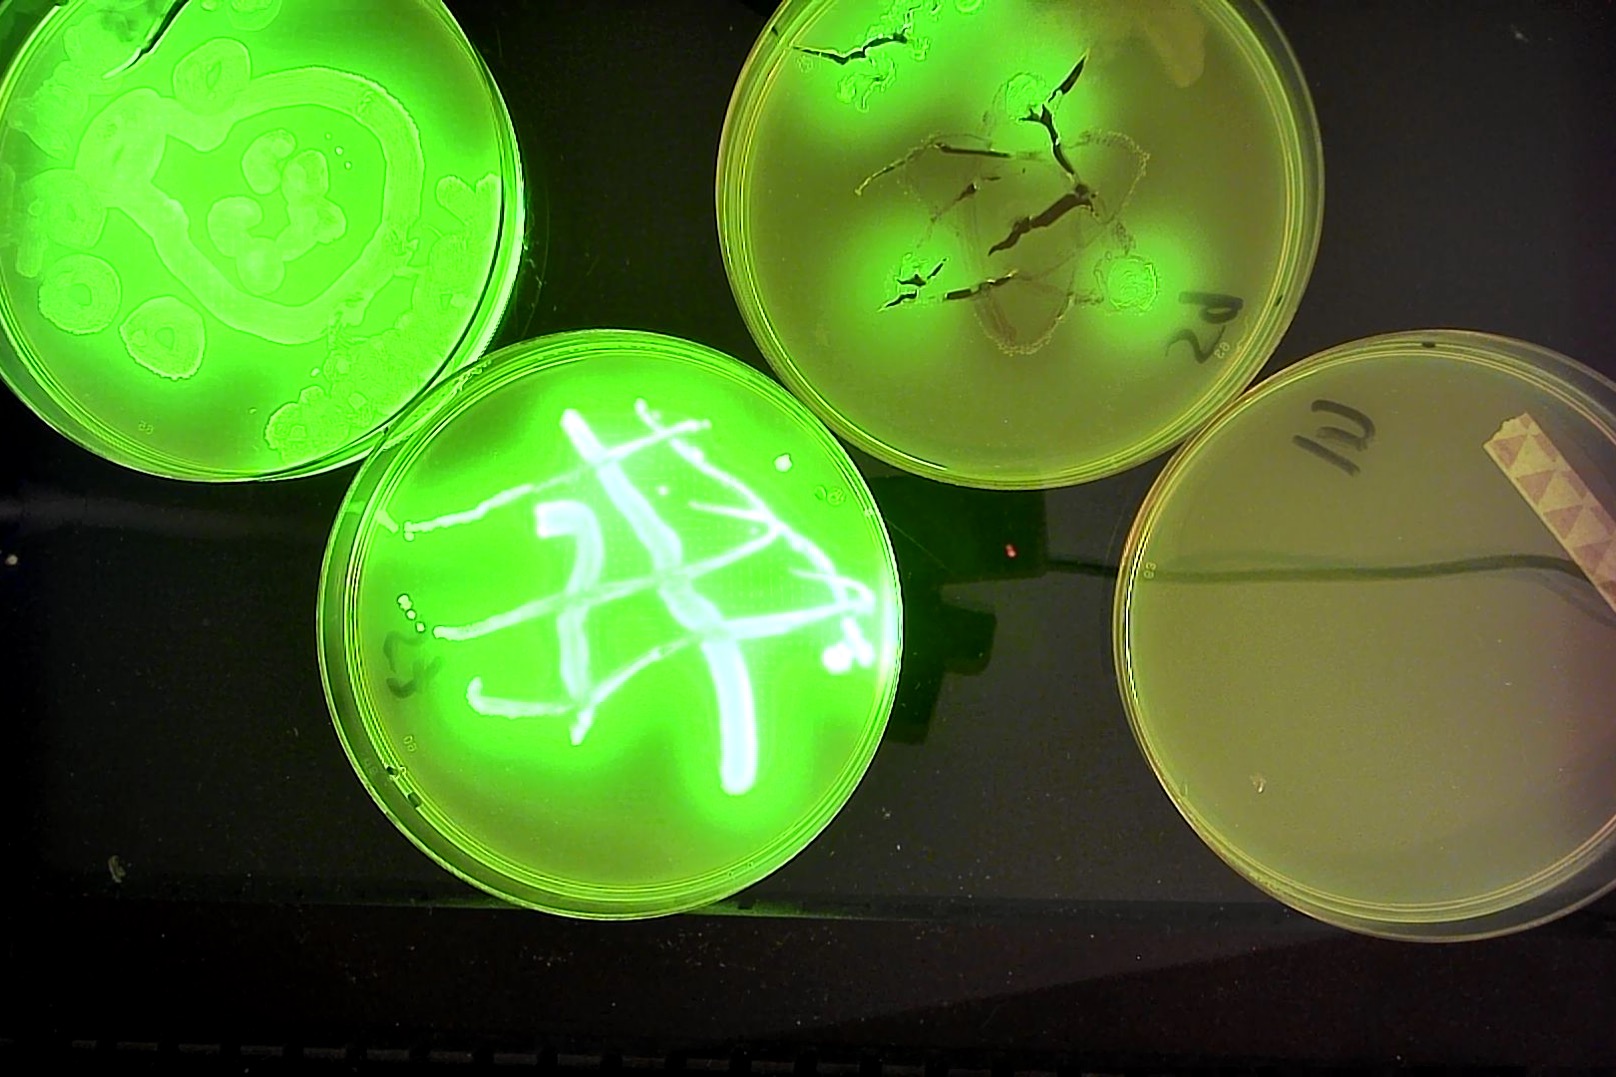
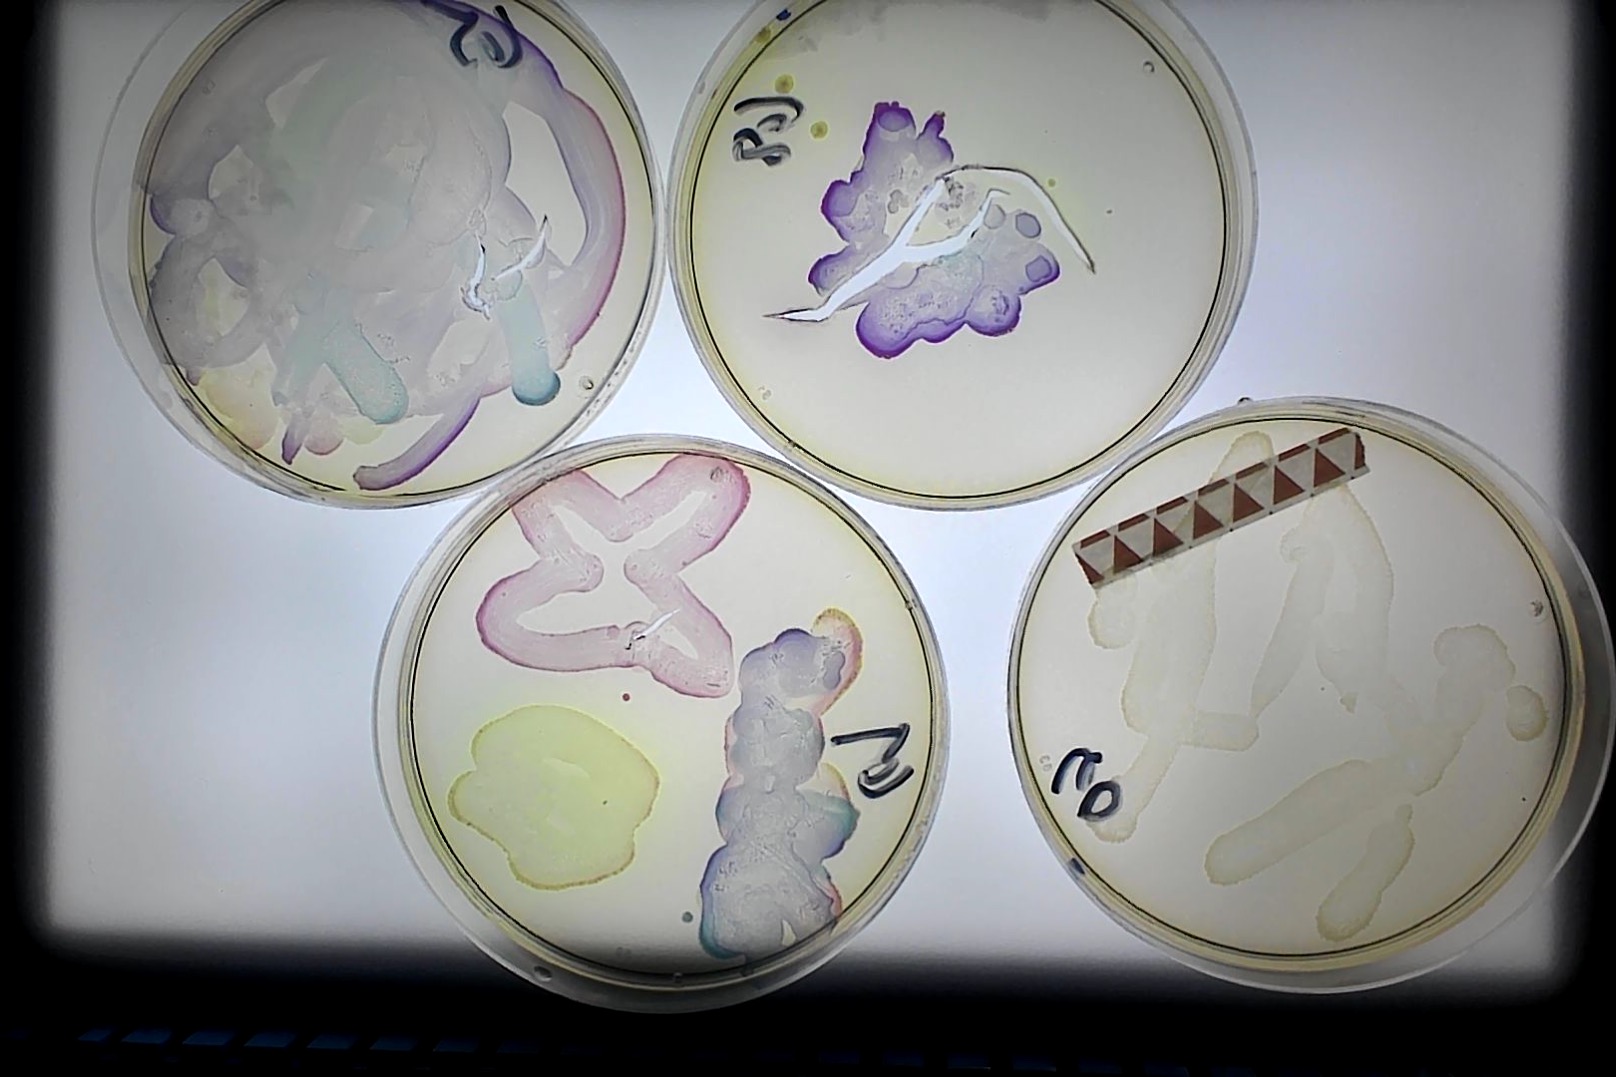
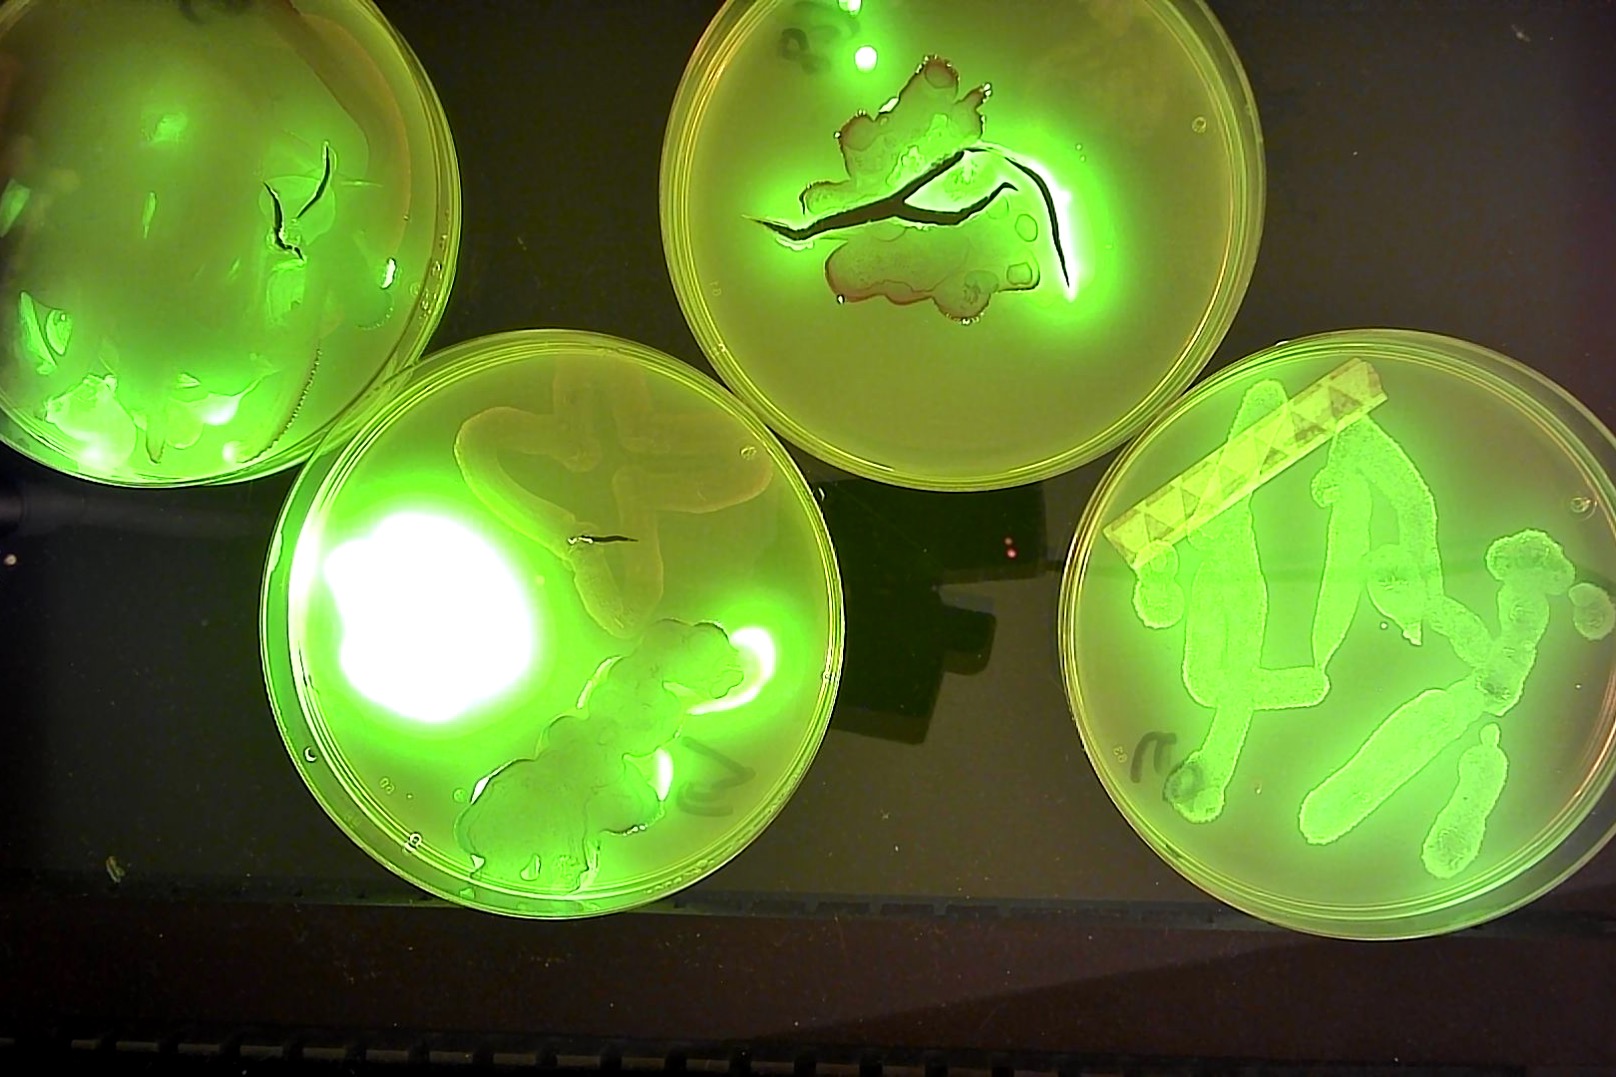
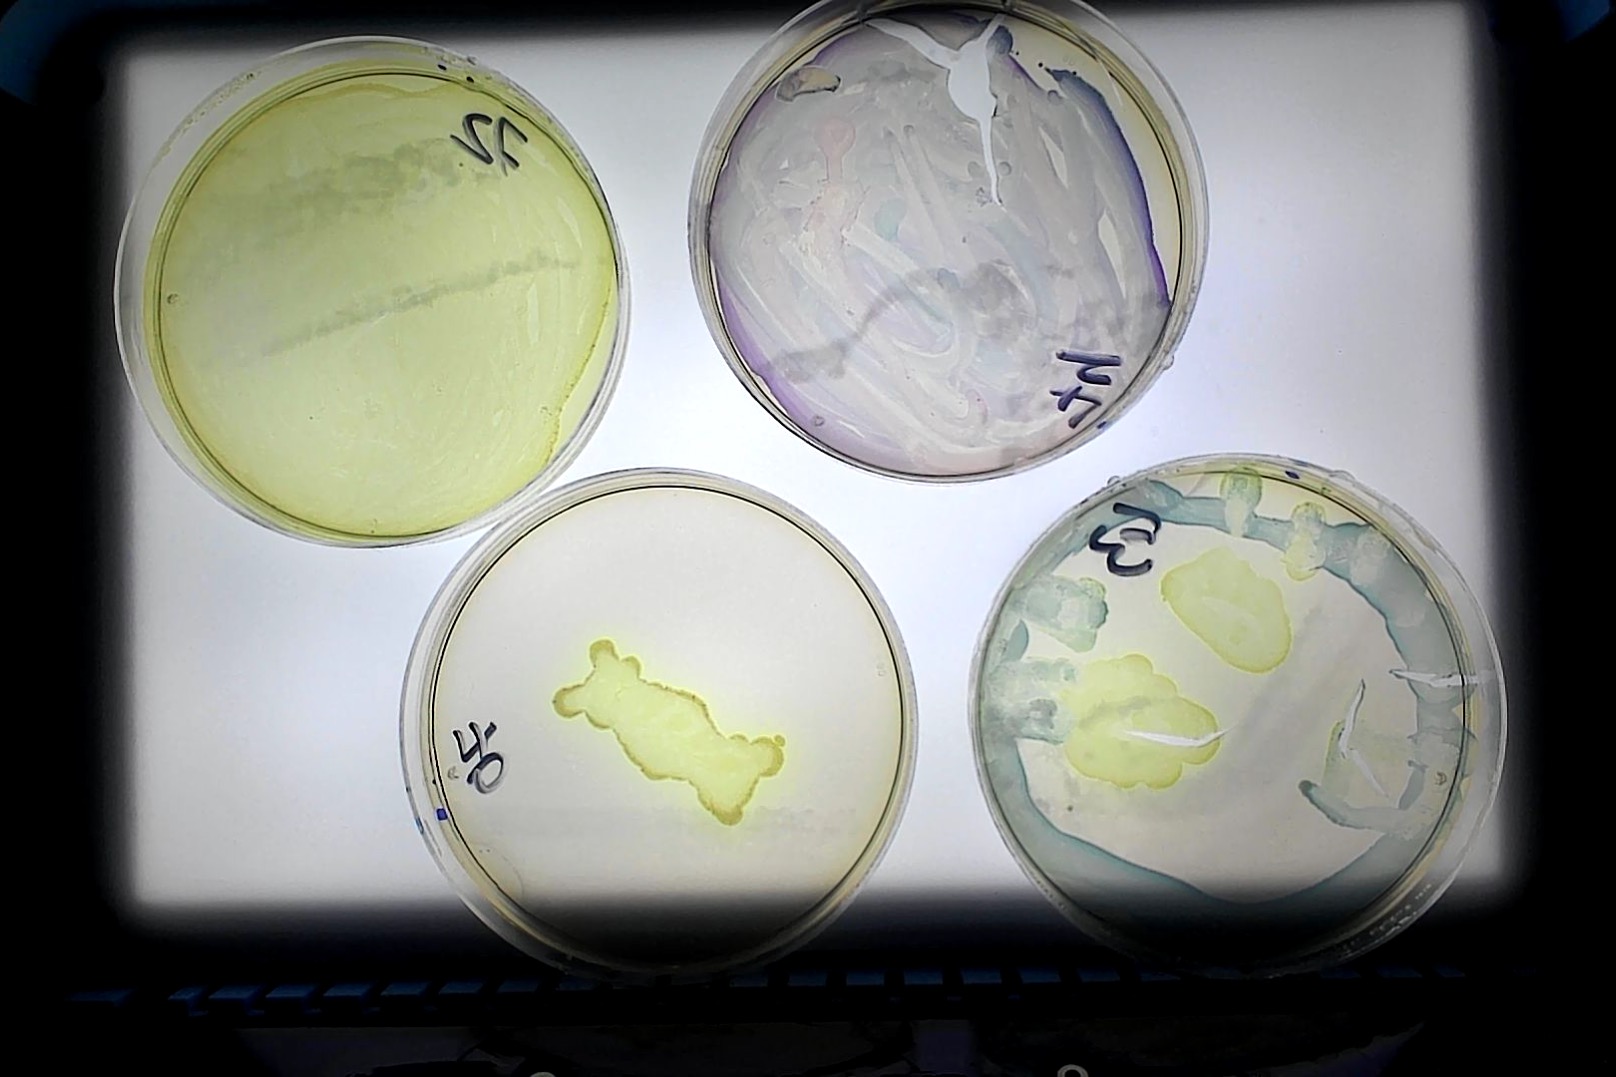
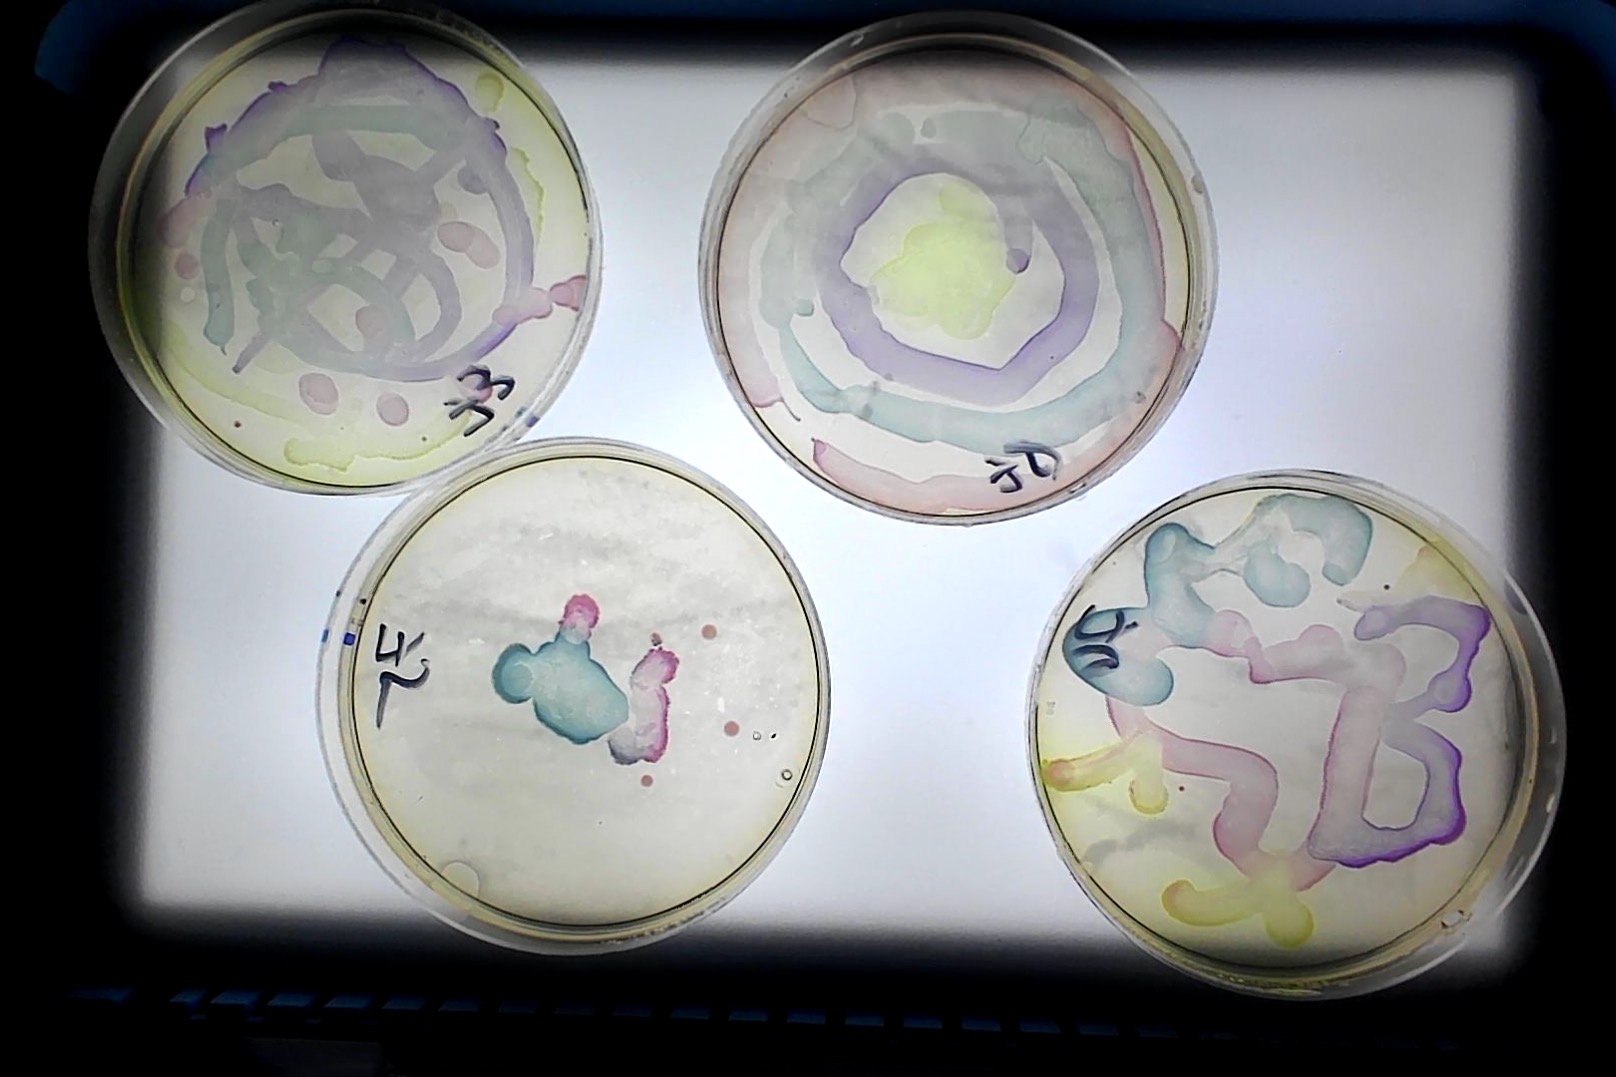
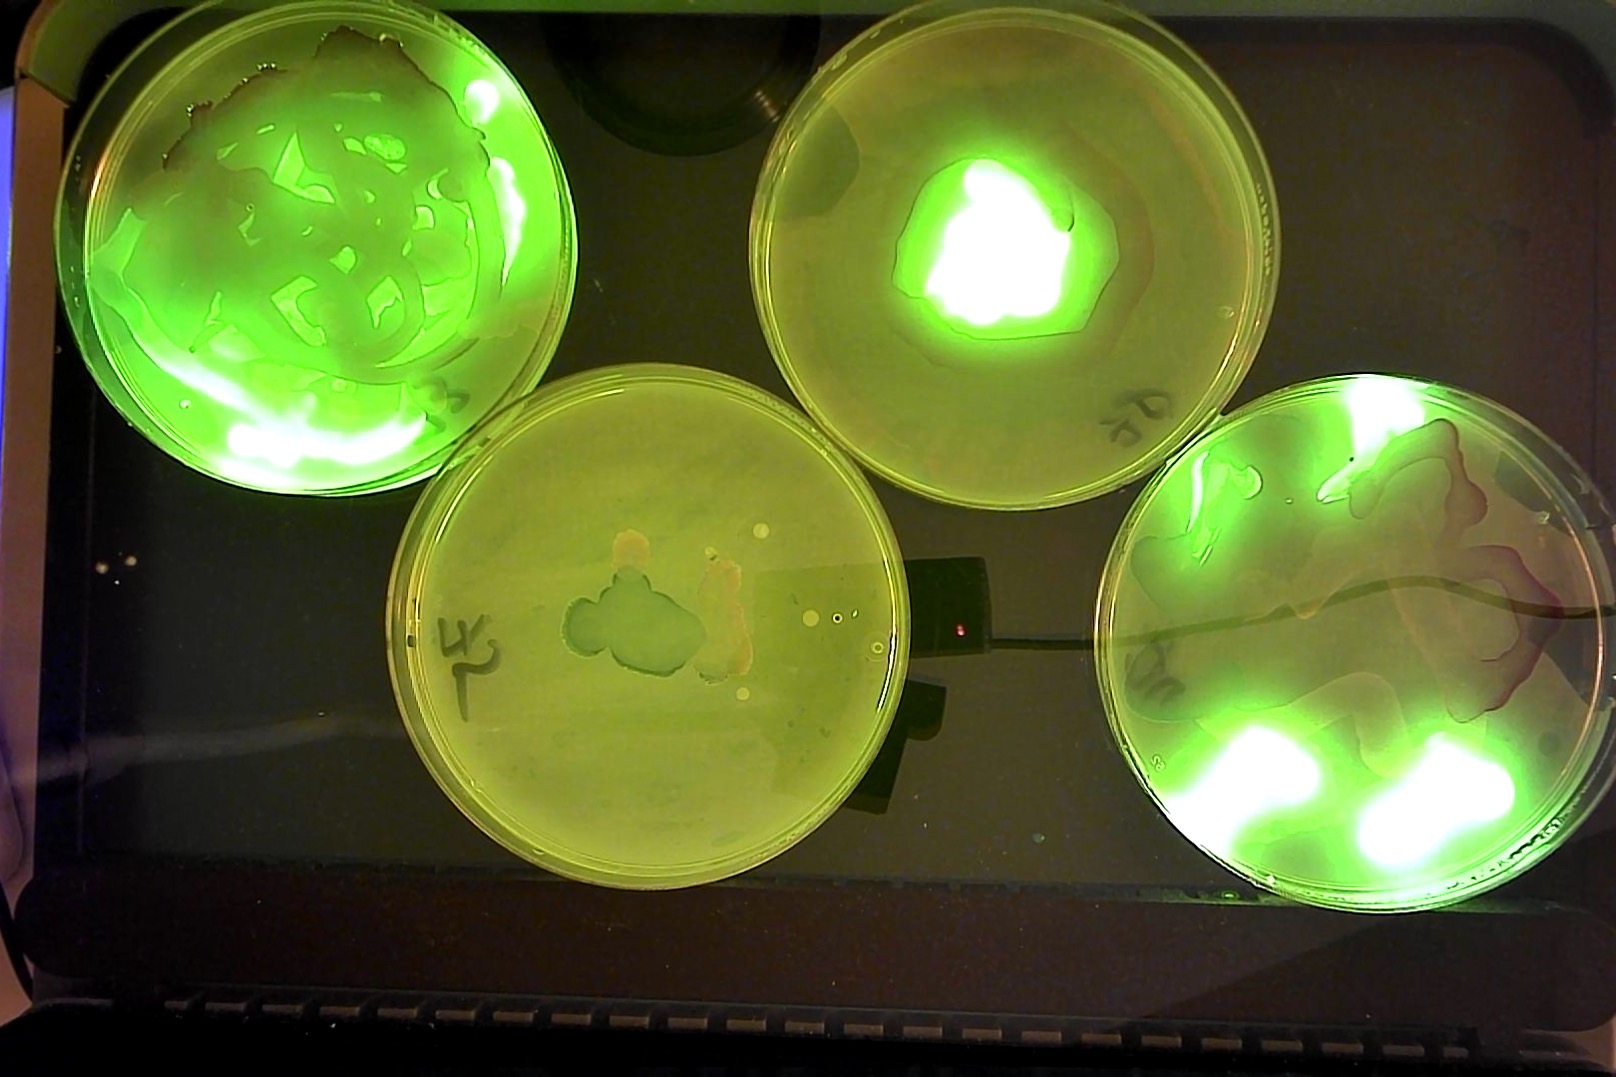
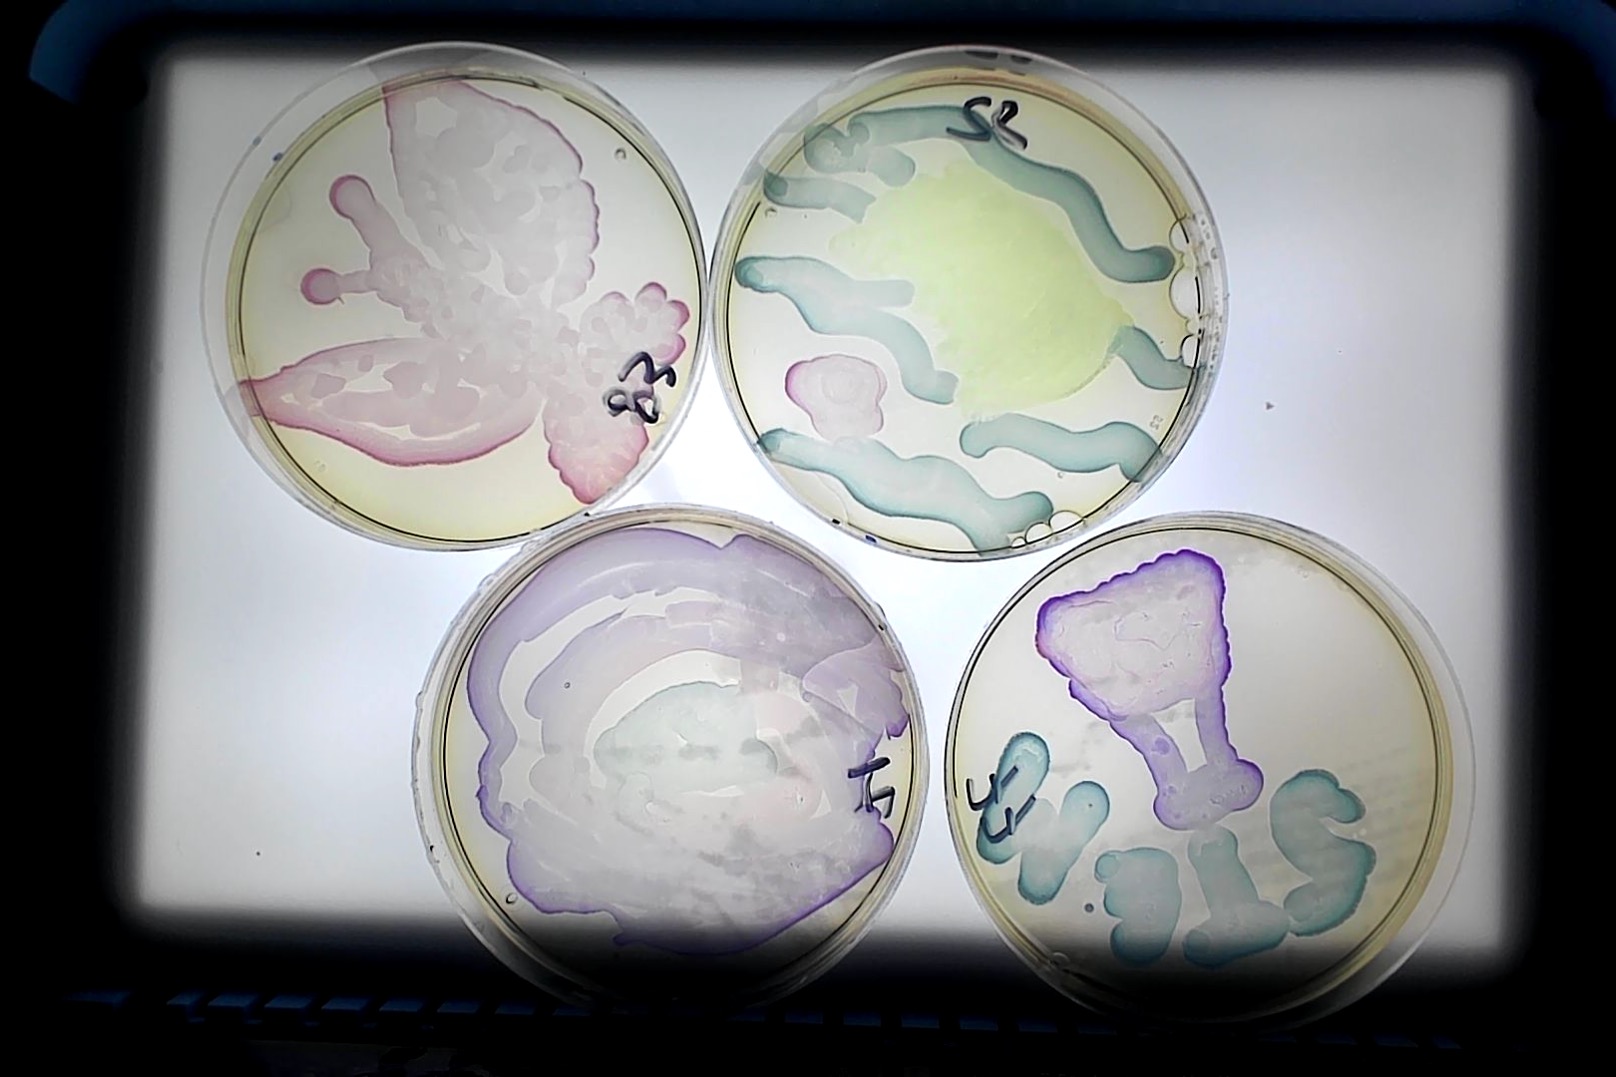
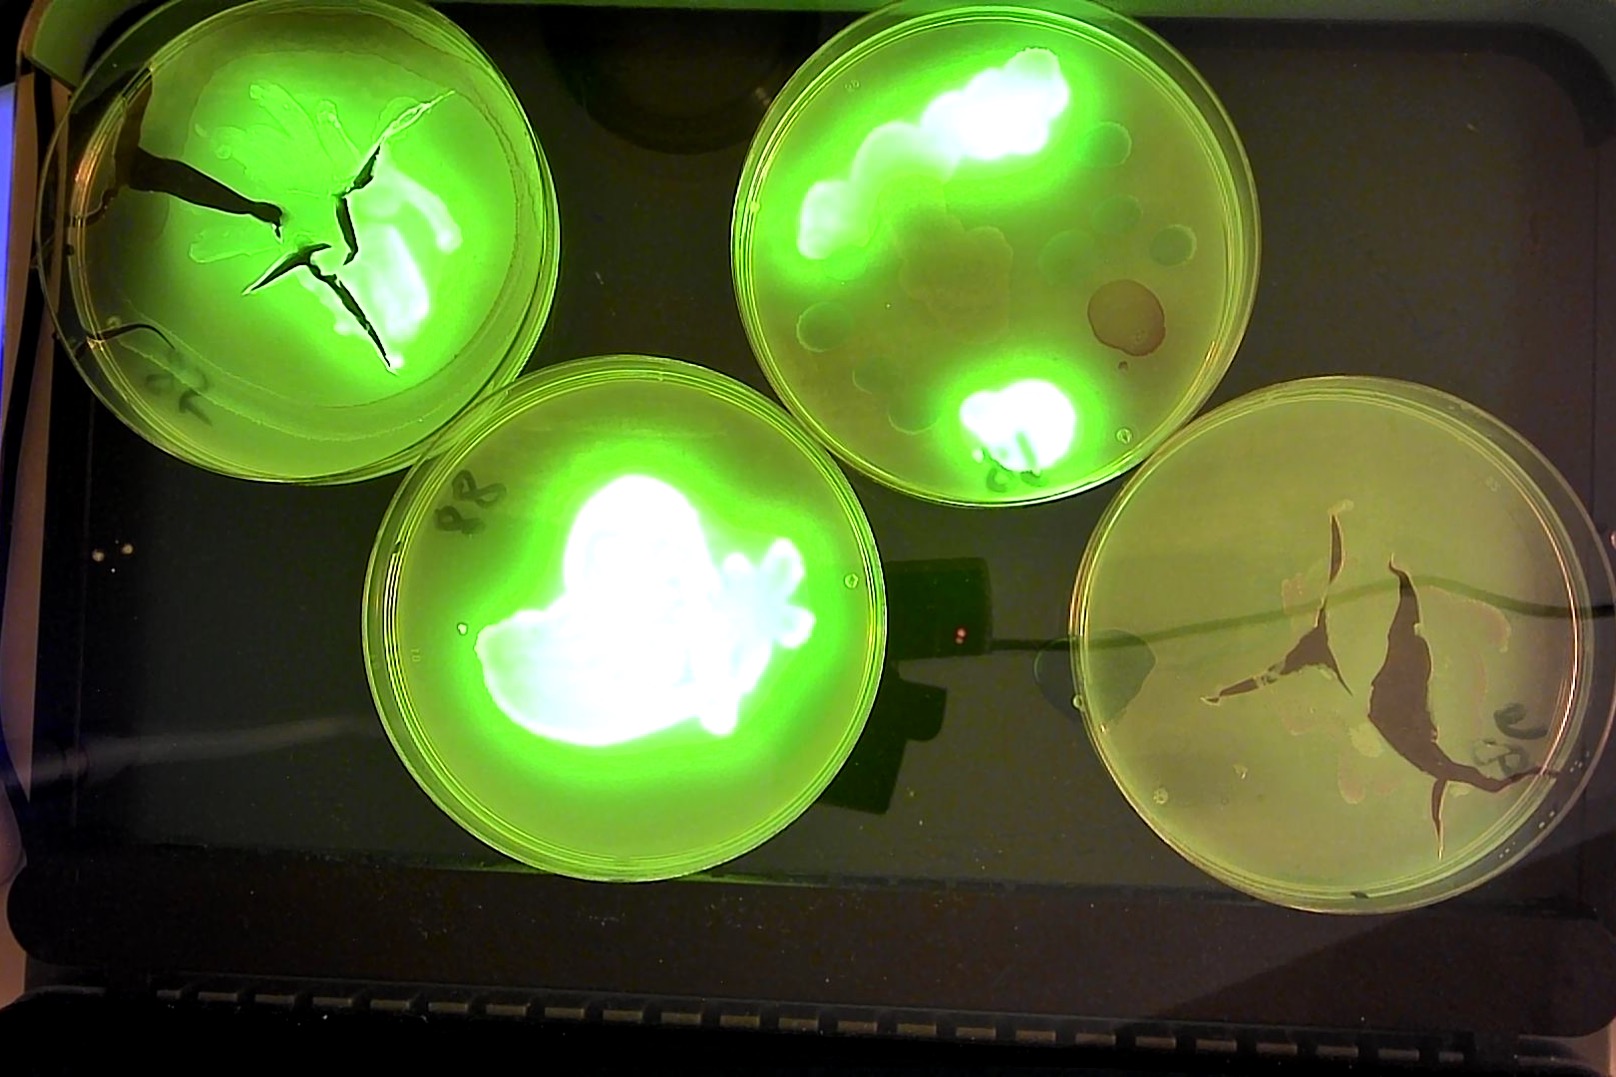
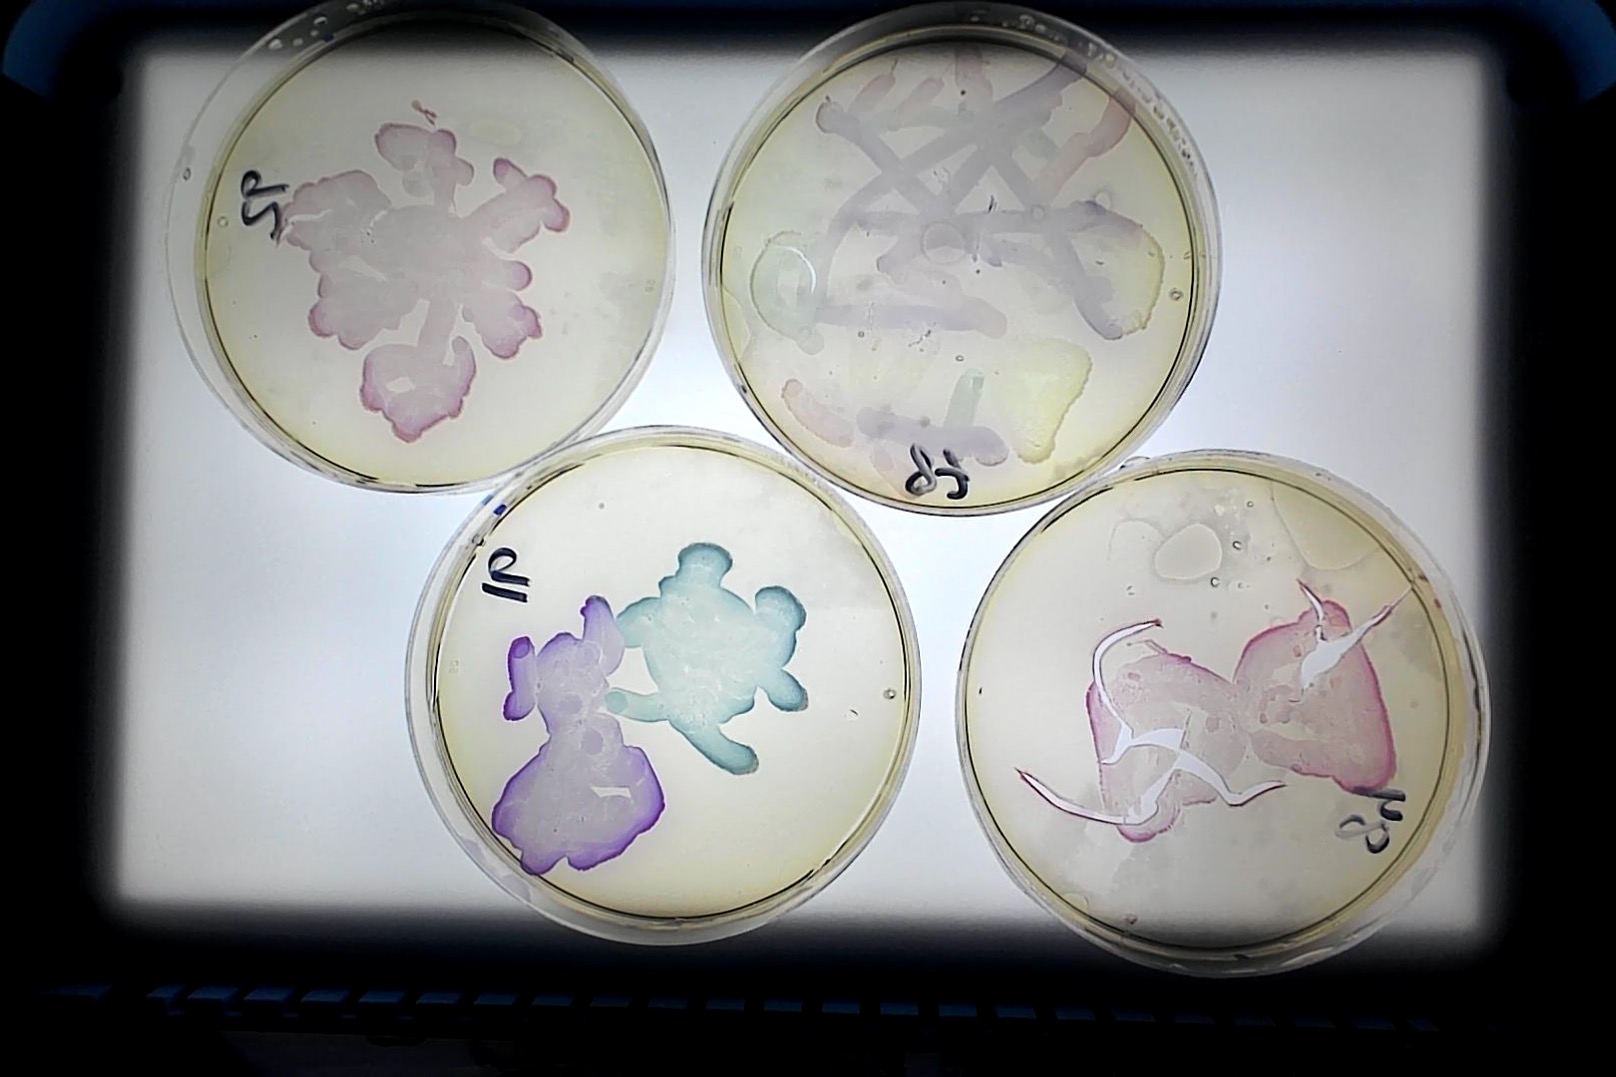
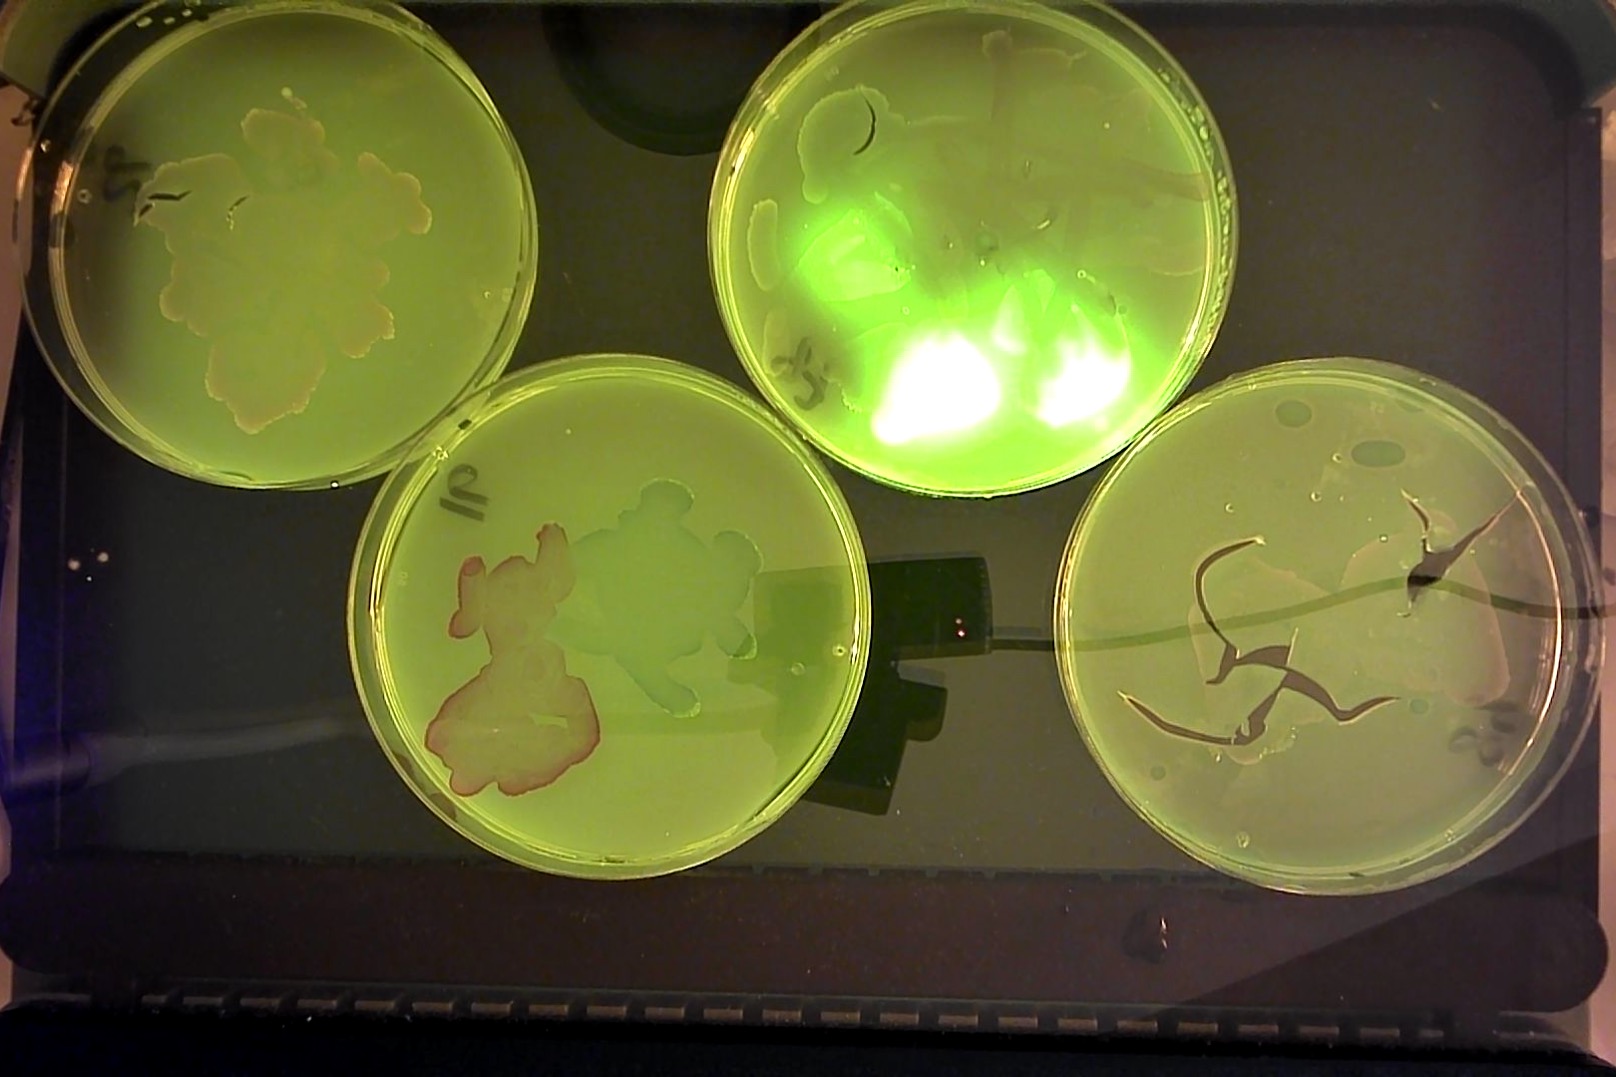
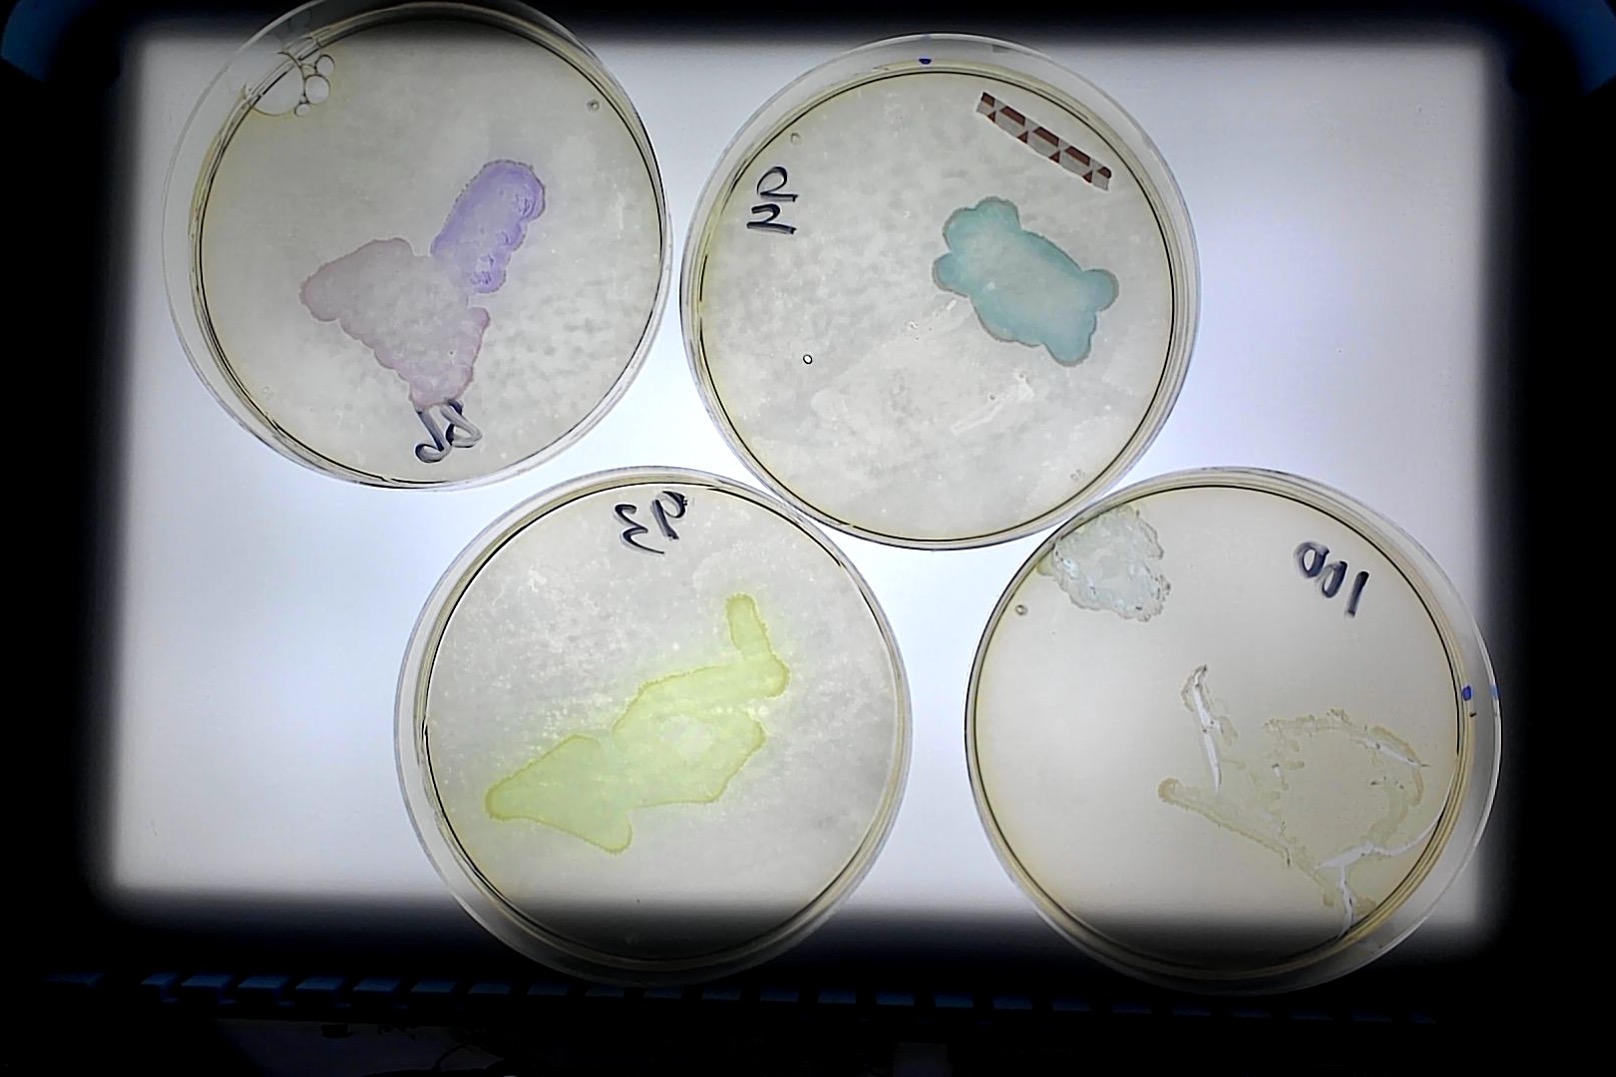
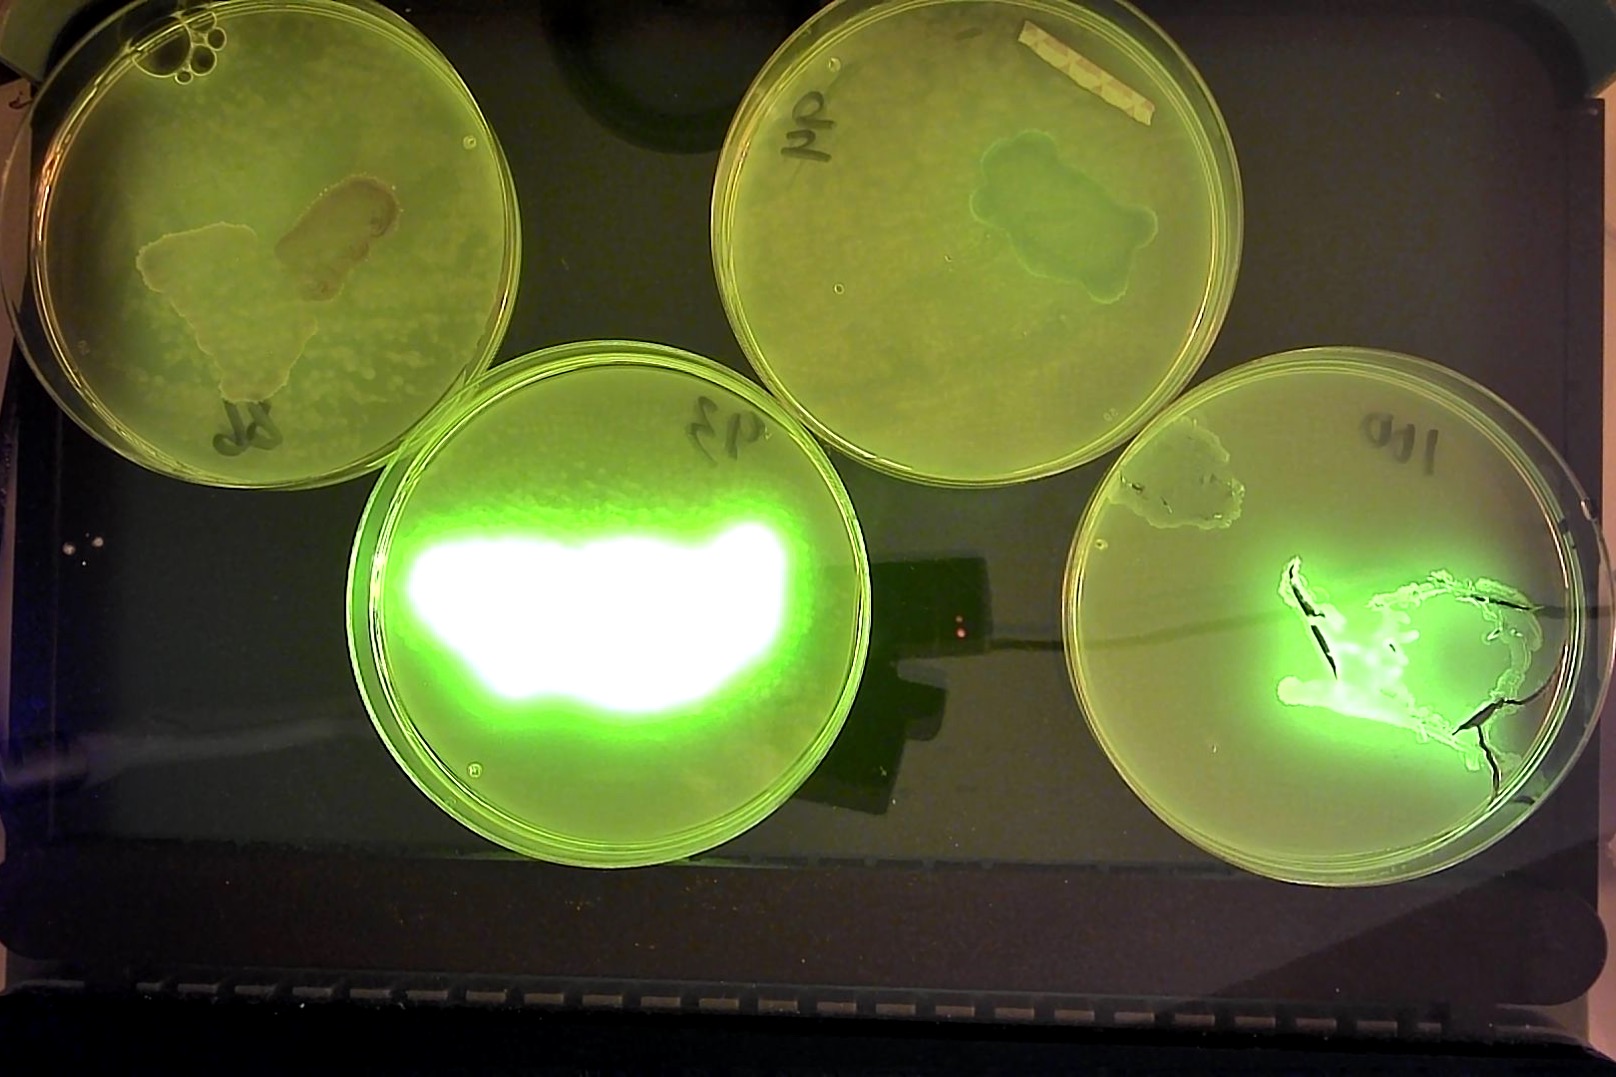

On March 17th 2023, Edvotek was invited by the Bayard Rustin Elementary School PTA to share a demonstration at the reimagined STEAM Fair and Expo. We were so impressed that there were nearly 70 posters of science projects from the student researchers at the school. Dr. Snowflack, a scientist at Edvotek and a parent at BRES, said, “I was blown away by the incredible creativity and scientific curiosity on display at the BRES science fair. It’s truly inspiring to see such young minds exploring and discovering the wonders of the world around them, and I can’t wait to see what they discover next.” We decided to share one of our favorite outreach activities — agar art! We thought this was the perfect activity for this event because agar art is a STEAM activity that uses living microbes to create living masterpieces, connecting arts to the science curriculum, encouraging out of the box thinking, and fostering a love of creativity. Plus, it helps make the microbiology lesson fun and interactive.
At the event, we used the BactoBeads from our Agar Art Kit to make bio-paints. The paints are made from E. coli bacteria that have been transformed with a plasmid to make colorful proteins. We like using this kit because it is quick and easy to create art with clear lines and bright pink, purple, blue, or green colors. Making the paints was simple. We added the beads to a nutrient broth mixture and let it sit for 30 minutes before putting it into small tubes. During the event, everyone was given a number on their petri plate, which acted as their canvas for creating agar art. Students planned their designs on a piece of paper before they transferred the bacteria onto the plate using a loop or a cotton swab like using a paintbrush to paint. The plates were taken back to Edvotek’s Rockville headquarters and left to incubate overnight at 37C. Once the incubation was over, we took pictures of the fantastic artwork created by the attendees. Below are the pictures from the event. If you would like photos of your plates, please contact Dr. Snowflack at programs@BRESPTA.org.

Thank you to all our amazing artists for showing up and sharing your talents with us! We can’t wait to see what you create in the future!

